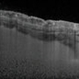

-
By Mallika Goyal, MD
Apollo Health City
Co-author(s): Sridhar A, MD - Uploaded on Nov 3, 2012.
- Last modified by Chayal Patel on Nov 27, 2012.
- Reviewed by Chayal Patel
- Rating
- Appears in
- Endogenous endophthalmitis following meningitis
- Condition/keywords
- endogenous endophthalmitis, resolution of abscesses, oral levofloxacin
- Photographer
- Mallika Goyal, MD
- Imaging device
- Fundus camera
- Description
- Right eye of a 19-year-old immunocompetent gentleman with bilateral retinal abscesses and haemorrhages 4 weeks following treatment for meningitis. Image shows resolution of abscesses with oral levofloxacin alone without any intraocular intervention.


 Initializing download.
Initializing download.